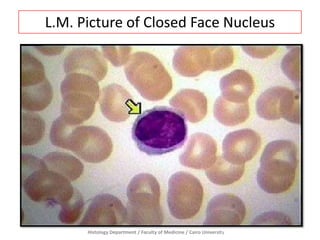
L.M. Picture of Closed Face Nucleus

Histology Department / Faculty of Medicine / Cairo University
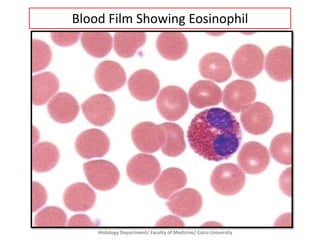
Blood Film Showing Eosinophil

Histology Department/ Faculty of Medicine/ Cairo University
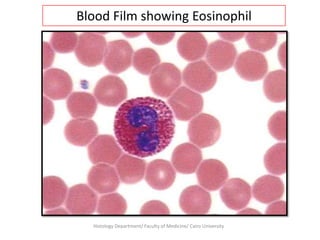
Blood Film showing Eosinophil

Histology Department/ Faculty of Medicine/ Cairo University
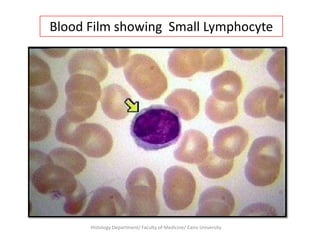
Blood Film showing Small Lymphocyte

Histology Department/ Faculty of Medicine/ Cairo University
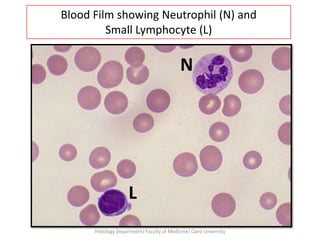
Blood Film showing Neutrophil (N) and
Small Lymphocyte (L)

N

L
Histology Department/ Faculty of Medicine/ Cairo University
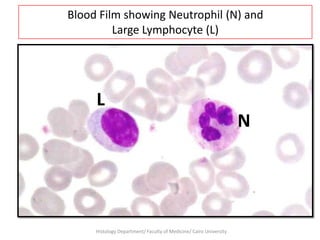
Blood Film showing Neutrophil (N) and
Large Lymphocyte (L)

L
N

Histology Department/ Faculty of Medicine/ Cairo University
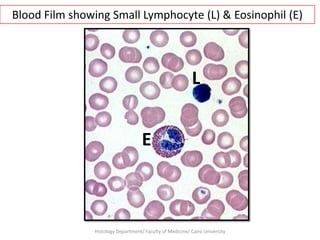
Blood Film showing Small Lymphocyte (L) & Eosinophil (E)

L
E

Histology Department/ Faculty of Medicine/ Cairo University
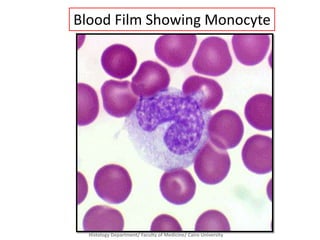
Blood Film Showing Monocyte

Histology Department/ Faculty of Medicine/ Cairo University
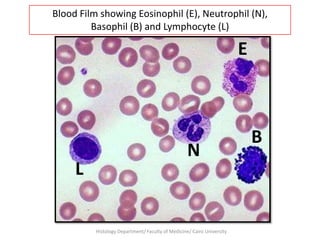
Blood Film showing Eosinophil (E), Neutrophil (N),
Basophil (B) and Lymphocyte (L)

E

L

N

Histology Department/ Faculty of Medicine/ Cairo University

B

This document contains over 100 images from the Histology Department of Cairo University's Faculty of Medicine. The images show microscopic views (LM and EM) of various cell structures and tissues, including nuclei, cell membranes, mitochondria, endoplasmic reticulum, Golgi apparatus, lysosomes, epithelial tissues, connective tissues, blood cells, and more. The images are intended to provide examples for educational use in the study of histology and cell and tissue structures.